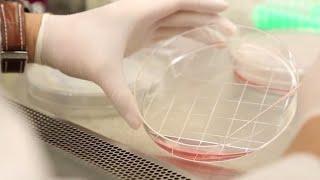

Irb
How IRBs Protect Human Research Participants
U.S. Department of Health and Human Services
83K
278,163
6 лет назад
Institutional Review Board (IRB) - Institutional Review Board, Ethics Committee
Precision Health
2K
5,707
4 года назад
How It Works: Institutional Review Board IRB in Human Performance Research
Exos
50
168
1 месяц назад
IRB 7710 and IRB 7720 – a new era of flexibility alongside improved performance and sustainability
ABB Robotics
1K
3,766
10 месяцев назад
IRB INFRA Share Latest News,IRB INFRA Share News Today,IRB INFRA Share Price,IRB INFRA Share Target
Stock Market Teach
80
267
2 дня назад
2024 SHARKSKIN Australian IRB Championships - Opens Finals
Surf Life Saving Australia
836
2,786
7 месяцев назад
IRB INFRA Share Analysis | IRB INFRA Share | irb infra Share Latest News, IRB SHARE NEWS
Trading Burner
323
1,078
55 лет назад
Passingout parade 2022 #indian #keralapolice #passingoutparade #police #keralagodsowncountry #irb
Sarath Lal sudarsan
30K
100,900
2 года назад
Guiding Principles of Institutional Review Boards (IRB)
Johns Hopkins Medicine
18K
61,265
9 лет назад
Сейчас ищут
Irb
Third Eye Security Control Equipment Llc
Rob Bob S Aquaponics Backyard Farm
Fsuip
J M Pool Company
Agent Shannon Pyatt
Youtube Лучшее
Aftab Ahmad
Tpm Top Persian Music
Fachadas De Casas Com Garagem
Fineline Records
Troubleshooting Hikvision Onvif Issues
Ummon Zohid 2024
Judges Matter
Health Today
Roni Skater
Streaming On Peacock New
Ultracart Review
Hyperlink Html
Madheena ന ല വ
Pound Cake Queen
Xmhadz
Hikvision Ip Camera Onvif Tutorial
Family Friendly Films
Le Monde Du Yachting
O Round The World
Dslrcarp Tv
Madison Films
Physik Instrumente Usa Precision Motion Control
Mariano Osorio Cruz Azul
Tina Smith For Minnesota
Skinfiniti With Dr Jaishree Sharad
Irb. Смотреть видео: How IRBs Protect Human Research Participants, IRB What Is IRB, Institutional Review Board IRB Institutional Review Board Ethics Committee, How It Works Institutional Review Board IRB In Human Performance Research.